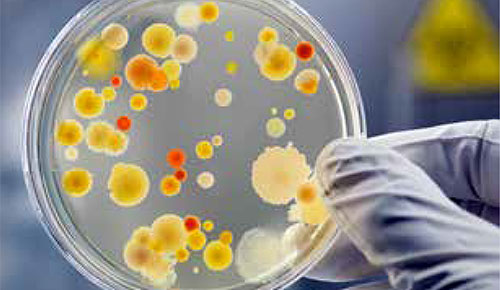
Derivadas

Si eres docente inicia sesión o regístrate para trabajar con tus alumnos a distancia.
Matemáticas 2 BA LOMLOE 2023

1.
Límites y continuidad
2.
Derivadas

3.
Representación de funciones

4.
Integrales

5.
Matrices y determinantes

6.
Sistemas de ecuaciones

7.
Vectores en el espacio

8.
Geometría del espacio

9.
Probabilidad

10.
Distribuciones de probabilidad
SITUACIONES DE APRENDIZAJE

1.
¿Cuál es el alma de los pueblos?

2.
¿Qué son las ciudades sostenibles?
PAU 2025

Prácticas de Matemáticas para la PAU 2025


Última actualización del borrador:

Busca y añade actividades
Libro:
Unidad:
Apartado:
Texto:
Tema:
Subtema:
Grado de dificultad:



















